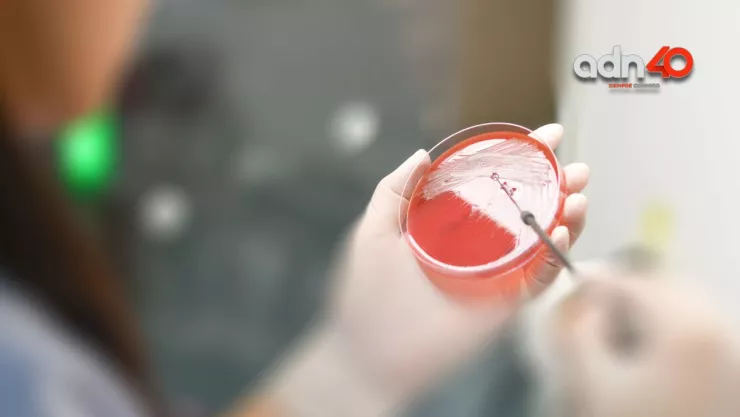
Meningitis aséptica en México

Este miércoles 23 de noviembre la Secretaría de Salud del estado de Durango, dio a conocer que se reportó un deceso más por meningitis aséptica en el país, esto luego de que muriera un hombre que se encontraba hospitalizado por esta enfermedad.
De acuerdo con la información dada a conocer por las autoridades del estado antes mencionado, la muerte por esta enfermedad se registró en un hombre de 47 años de edad que había sido sometido a una cirugía de tibia y peroné.
Primer caso de viruela del mono en México
Sin embargo meses después de esta intervención médica, el paciente contrajo meningitis aséptica causándole la muerte.
Se detalló que el paciente estaba internado en el Hospital General 450, además de que este miércoles 23 de noviembre las autoridades de salud del estado confirmaron su deceso.
Actualización casos por meningitis. pic.twitter.com/j1dJvQNKvq
— Secretaría de Salud (@SSDurango) November 23, 2022
¿Es contagiosa la meningitis aséptica?
De acuerdo con la información dada a conocer por la Secretaría de Salud de Durango, de momento cuentan con un total de 61 casos confirmados así como 10 muertes por esta enfermedad.
Fue el pasado 10 de noviembre que las autoridades locales detallaron que los contagios fueron originados por un hongo, por lo cual se sometió a los pacientes a un tratamiento inmediato para revertir la enfermedad.
Pese a los casos confirmados de contagios, es importante señalar que la Secretaría de Salud de Durango señala que la meningitis aséptica no es contagiosa, lo cual es un llamado a la población para no caer en pánico.
Es importante señalar que de momento la Comisión Federal para la Protección contra Riesgos Sanitarios (Cofepris), se encuentra investigando el por qué se dio este brote de la enfermedad en los hospitales de Durango.
De momento el resto de las personas con esta enfermedad se encuentran bajo tratamiento médico especial en el estado.
adn40 siempre conmigo. Suscríbete a nuestro canal de Google News y lleva la información en tus manos.
ytc